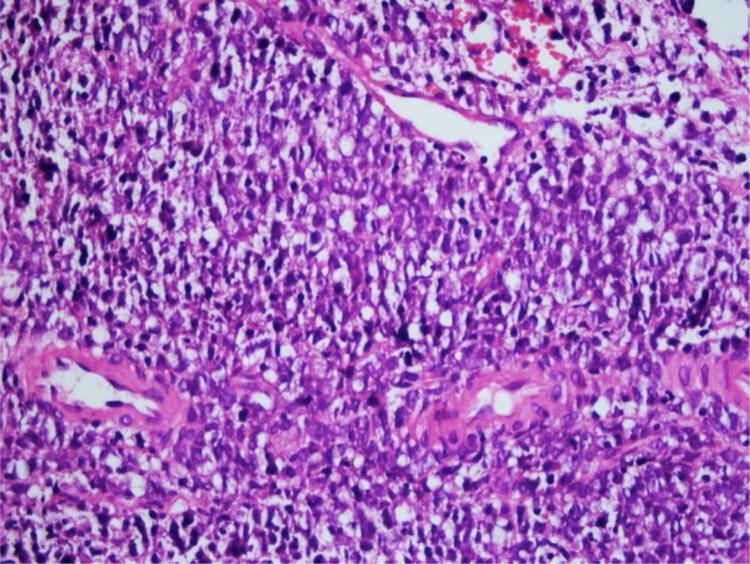
https://cdn.ncbi.nlm.nih.gov/pmc/blobs/936c/9444721/6789ef377197/gr3.jpg

Hoarseness: an unusual presentation of primary thyroid lymphoma with laryngeal infiltration.
作者信息
Gökdoğan Ozan, Koybasioglu Ahmet, Ismail Erkin, Erol Timucin, Alagoz Gokcen, Yagmurlu Banu, Komurcu Seref
机构信息
Ankara Memorial Hospital, Department of Otorhinolaryngology, Ankara, Turkey.
Ankara Memorial Hospital, Department of Otorhinolaryngology, Ankara, Turkey.
出版信息
Braz J Otorhinolaryngol. 2016 Nov-Dec;82(6):737-740. doi: 10.1016/j.bjorl.2015.05.006. Epub 2015 Sep 7.
Abstract
摘要